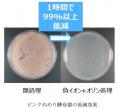
世界初、負イオンの併用によるオゾン酸化作用の向上メ

世界初、負イオンの併用によるオゾン酸化作用の向上メカニズムを解明
三菱電機株式会社

付着ウイルス・菌・臭気を低減し、安心・安全で快適な室内環境の提供に貢献
[画像1:
https://prcdn.freetls.fastly.net/release_image/120285/337/120285-337-74f30ac274cb2c82e138100c76cf032f-1214x572.jpg?width=536&quality=85%2C75&format=jpeg&auto=webp&fit=bounds&bg-color=fff ]
三菱電機株式会社は、国立大学法人東京科学大学(以下、Science Tokyo)生命理工学院の蒲池教授らと共同で、負イオンを併用することでオゾンの酸化作用を向上させるメカニズムを世界で初めて(※1)解明しました。これは、負イオンをウイルス・菌などの周囲に存在する水分に溶解させると、負イオン由来の硝酸系成分によりpHが低下するため、水分中のオゾンの酸化作用が高まり、低濃度オゾンでもウイルス・菌などに対し強力な低減効果を発揮することを明らかにしたものです。負イオンとオゾンを併用することで、オゾン濃度50ppb以下(※2)で、これまで報告(※3)してきた特定のウイルスに加えて、菌・臭気などに対する低減効果を確認しました。
近年、建物の高気密・高断熱化が進み、換気が不十分な屋内においては、衛生環境が悪化する懸念が高まっています。従来は、屋内の衛生環境を保つためにオゾンの酸化作用を利用してきましたが、オゾン単体では衛生性向上効果の持続性や安定性に課題がありました。また、オゾンの持つウイルス・菌などに対する低減効果は、負イオンを併用した場合に増加することや、pHによって変化することは知られていましたが、負イオンの化学種や、負イオンによるpHの制御効果は明らかではありませんでした。
今回、当社が培ってきたウイルス・菌・臭気の低減効果評価技術と、Science Tokyoが保有する放電活性種(※4)の分析・同定技術により、負イオンが水分中でpHを制御するプロセスを明確化し、負イオンの併用によるオゾン酸化作用を向上させるメカニズムを解明しました。さらに、ウイルスに加えて、試験片に付着した大腸菌や水回りのピンクぬめり酵母菌を1時間で99%低減、汗臭・生乾き臭を1時間で臭気強度1以上低下(※5)する効果を確認しました。
本開発成果の詳細は、12月15日から20日までハワイ(ホノルル)で開催される国際会議「Pacifichem(※6) 2025」で発表予定です。
今後も当社は、安心・安全で快適な室内環境の実現に向けて、革新的な技術の開発に取り組みます。
■開発の特長
1.負イオンの併用により、オゾン酸化作用を向上させるメカニズムを解明
・放電活性種の多角的な検証から、負イオンとオゾン照射後の水分に含まれている硝酸系イオンがpH低下を引き起こすことを解明
・大気中の低いオゾン濃度でも、pHが低下することで水分中のオゾンの溶存濃度が1.5倍となり、オゾンの酸化作用が向上
2.低いオゾン濃度で、室内の付着ウイルス・菌・臭気の低減を確認
・放電設計・制御技術を活かした、負イオンとオゾンを安定して発生するデバイス(※7)を開発
・50ppb以下の低いオゾン濃度で、試験片に付着した大腸菌、および水回りのピンクぬめり酵母菌を1時間で99%低減、試験布に付着した汗臭・生乾き臭においては、1時間で臭気強度1以上低下(臭気の90%以上低下に相当)
■役割分担
[表:
https://prtimes.jp/data/corp/120285/table/337_1_08da81584017368d70e17ced2e6a39d3.jpg?v=202512150415 ]
■特長の詳細
1.負イオンの併用により、オゾン酸化作用を向上させるメカニズムを解明
水分に溶解したオゾンは、高pH(塩基性条件下)で分解が促進されますが、低pH(酸性条件下)では分解が抑制されます。低濃度のオゾンを照射してウイルス・菌などにオゾンを作用させるためには、ウイルス・菌などの近傍の水分中での分解の抑制が重要であり、低pH環境が適しています。
今回、イオンクロマトグラフィーやラジカル種を特定するESR(※8)測定や、高反応性分子に対する蛍光分析など、放電活性種の多角的な検証から、負イオンとオゾンを照射した水分には硝酸系イオンが含まれていることを特定し、pH変化を引き起こすことを解明しました。
さらに、負イオンとオゾンを1時間照射した水分のpH測定では、中性のpH7から弱酸性のpH5まで低下することを確認するとともに、負イオンを併用しない場合と比べて溶存オゾン濃度が約1.5倍向上することを確認しました。
水分中での溶存オゾン濃度が高まることで、処理対象であるウイルス・菌などとオゾンの接触機会が高まり、酸化作用が向上する低減効果メカニズムを明らかにしました。
[画像2:
https://prcdn.freetls.fastly.net/release_image/120285/337/120285-337-0b50ba2c8bcbb0c5bf9bbae9a5015083-1220x442.jpg?width=536&quality=85%2C75&format=jpeg&auto=webp&fit=bounds&bg-color=fff ]
2.低いオゾン濃度で、室内の付着ウイルス・菌・臭気の低減を確認
本技術は、負イオンによる水分pH制御によって低濃度オゾンでも酸化作用を効率的に高めるため、50ppb以下の低いオゾン濃度においても、ウイルス・菌・臭気に対する高い低減効果を実現しました。
この技術を用いた50ppb以下の低いオゾン濃度での1時間処理において、これまでに報告してきた試験片に付着したウイルスの低減効果(99%)に加えて、試験片に付着した大腸菌、および水回りのピンクぬめり酵母菌を99%低減する効果を確認(※9)しました。また、試験布に付着した汗臭・生乾き臭についても、6段階臭気強度評価で1以上低下する効果を確認(※10)しました。これらの効果はいずれも、オゾン単独処理よりも高い低減効果を示しています。
[画像3:
https://prcdn.freetls.fastly.net/release_image/120285/337/120285-337-f0bbe68fb4f719bba9867a01aba59818-574x522.jpg?width=536&quality=85%2C75&format=jpeg&auto=webp&fit=bounds&bg-color=fff ]
[画像4:
https://prcdn.freetls.fastly.net/release_image/120285/337/120285-337-e799a2a6ccb8a0374ef54db4ca411441-1282x518.jpg?width=536&quality=85%2C75&format=jpeg&auto=webp&fit=bounds&bg-color=fff ]
■今後の予定・将来展望
学校、病院、オフィスなどの人が集まる空間や、リビング、キッチン、浴室などの生活空間に加え、自動車、電車、飛行機などの公共交通機関やシェアモビリティなどの移動空間におけるウイルスや菌、臭気の発生を抑えるため、デバイスの小型化や高効率化を目指します。また、各空間の特性に合わせた最適な除菌・脱臭ソリューションに向けた技術開発を加速し、安心・安全で快適な社会の実現に貢献します。
■三菱電機グループについて
私たち三菱電機グループは、たゆまぬ技術革新と限りない創造力により、活力とゆとりある社会の実現に貢献します。社会・環境を豊かにしながら事業を発展させる「トレード・オン」の活動を加速させ、サステナビリティを実現します。また、デジタル基盤「Serendie(R)」を活用し、お客様から得られたデータをデジタル空間に集約・分析するとともに、グループ内が強くつながり知恵を出し合うことで、新たな価値を生み出し社会課題の解決に貢献する「循環型 デジタル・エンジニアリング」を推進しています。1921年の創業以来、100年を超える歴史を有し、社会システム、エネルギーシステム、防衛・宇宙システム、FAシステム、自動車機器、ビルシステム、空調・家電、デジタルイノベーション、半導体・デバイスといった事業を展開しています。世界に200以上のグループ会社と約15万人の従業員を擁し、2024年度の連結売上高は5兆5,217億円でした。詳細は、
www.MitsubishiElectric.co.jpをご覧ください。
※1 2025年12月15日現在。当社調べ
※2 (公社)日本空気清浄協会の室内許容濃度(設計基準):オゾン濃度の平均値が50ppb(parts
per billion:10億分の1)以下であること
※3 防菌防黴学会誌 Vol.52,No.2 (2024):JEM1467に準じた23m3の試験室(約6畳)にて
ウイルス液を滴下した金属片に対して試験を実施
※4 放電により発生する化学種(電子、イオン、ラジカル、励起状態の分子などが含まれる)
※5 6段階臭気強度にて評価。「臭気強度1低下」は、臭気90%の低減に相当
※6 ハワイのホノルルで5年ごとに開催される世界最大級の化学分野の国際会議
https://pacifichem.org
※7 特許第7370496号
※8 Electron Spin Resonance(電子スピン共鳴):不対電子を持つ化合物を検出し、放電活性種中
の活性酸素種などを評価する手法
※9 約12Lの密閉空間にて菌液を滴下した樹脂片に対して試験を実施
※10 約4.6m3の試験室にて臭気成分を付着した生地片に対して試験を実施
<お客様からのお問い合わせ先>
三菱電機株式会社 先端技術総合研究所
〒661-8661 兵庫県尼崎市塚口本町八丁目1番1号
FAX 06-6497-7285
https://www.MitsubishiElectric.co.jp/corporate/randd/inquiry/index_at.htmlプレスリリース提供:PR TIMES

記事提供:PRTimes
![]()